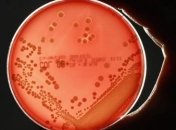
Ученые создали антибиотик, который убивает опасные бактерии

Новости по теме Антибиотик
-

Жиравецкий не считает, что коронавирус во всех случаях нужно лечить только чаем и витаминами
-

Алгоритм глубинного изучения открыл новые антибиотики, которые могут лечить более 30 лекарственно-устойчивых заболеваний.
-

Новый тип антибиотиков выделяют бактерии, которые живут внутри червей, а эти черви живут только в насекомых.
-

Учитывая, что антибиотики теперь переопределены, особенно в таких условиях, как грипп, простуда и боль в ушах, нам пора переходить к альтернативной медицине и естественным антибиотикам.
-

Ученые обнаружили новый антибиотик в тропическом лесу в Мексике.
-

Согласно исследованиям, реки по всему миру загрязнены антибиотиками, которые превышают пороги экологической безопасности до 300 раз.
-

Эти дары природы обладают высокими антибактериальными, противогрибковыми, противовирусными свойствами и способны защитить человеческий организм от вредоносных бактерий.
-

Новый антибиотик кедарцидин - эффективное вещество в борьбе с раковыми клетками.
-

Некоторые микробы, попадающие в наш организм, могут "убить" своих друзей - полезные бактерии, что негативно скажется на общем самочувствии.
-

Само по себе соединение не является готовым к употреблению препаратом, но может стать основной для разработки нового класса антибиотиков.
-
В мире растет проблема устойчивости супербактерий.
-

Недавнее исследование показало, что рты драконов Комодо содержат до 57 видов опасных бактерий.
-

Ученые обнаружили мощный антибиотик в человеческом организме.
-

Попрощайтесь с любыми воспалениями и инфекциями
-

О полезных свойствах чеснока для крепкого здоровья.
-

Естественный фруктовый антибиотик.



